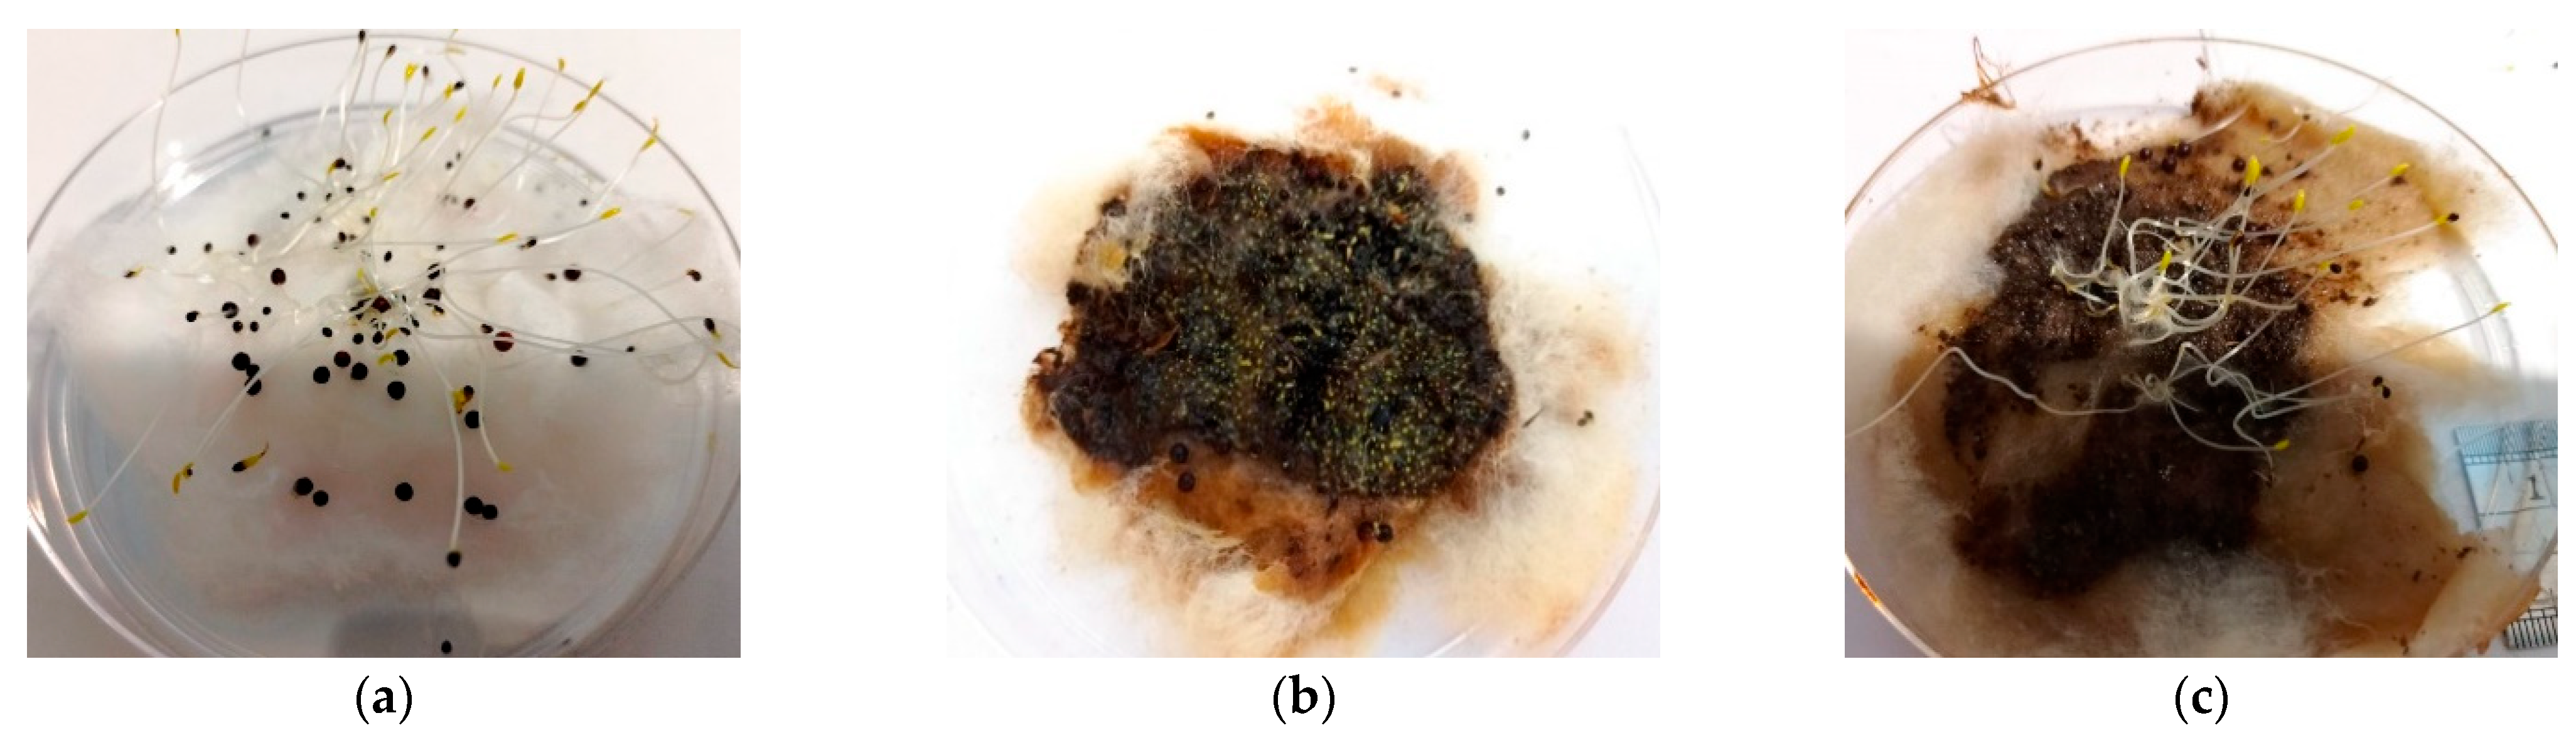
Bioengineering 10 00938 g005a Bioengineering 10 00938 g005a

Aerated Static Pile Composting for Industrial Biowastes: From Engineering to Microbiology
Abstract
1. Introduction
2. Materials and Methods
2.1. Materials
2.2. Characterizations and Measurements
2.3. Composting Method
2.4. Maturity Tests
2.5. Culture-Independent DNA Sequencing
2.5.1. Random Sampling
2.5.2. DNA Extraction and Verification
2.5.3. Metagenomic Analysis of Bacterial and Fungal Diversity in Compost
3. Results and Discussion
3.1. Quantities and Composition of the Feedstock
3.2. Temperature Profile and Maturity
3.3. Temperature Profile and Maturity
3.4. Further Discussions and Recommendations
4. Conclusions
Author Contributions
Funding
Institutional Review Board Statement
Informed Consent Statement
Data Availability Statement
Conflicts of Interest
References
- Mak, T.M.; Xiong, X.; Tsang, D.C.; Iris, K.; Poon, C.S. Sustainable food waste management towards circular bioeconomy: Policy review, limitations and opportunities. Bioresour. Technol. 2020, 297, 122497. [Google Scholar] [CrossRef]
- Ambec, S.; Cohen, M.A.; Elgie, S.; Lanoie, P. The Porter hypothesis at 20: Can environmental regulation enhance innovation and competitiveness? Rev. Environ. Econ. Policy 2020, 7, 1. Available online: https://www.journals.uchicago.edu/doi/abs/10.1093/reep/res016?journalCode=reep (accessed on 30 November 2022).
- Adhikari, B.K.; Barrington, S.; Martinez, J.; King, S. Effectiveness of three bulking agents for food waste composting. Waste Manag. 2009, 29, 197–203. [Google Scholar] [CrossRef]
- Awan, U.; Kraslawski, A.; Huiskonen, J.; Suleman, N. Exploring the locus of social sustainability implementation: A South Asian perspective on planning for sustainable development. In Universities and Sustainable Communities: Meeting the Goals of the Agenda 2030; Springer: Cham, Switzerland, 2020; pp. 89–105. [Google Scholar]
- Rahman, M.M.; Mat, K.; Ishigaki, G.; Akashi, R. A review of okara (soybean curd residue) utilization as animal feed: Nutritive value and animal performance aspects. Anim. Sci. J. 2021, 92, e13594. [Google Scholar] [CrossRef]
- Choi, I.S.; Kim, Y.G.; Jung, J.K.; Bae, H.-J. Soybean waste (okara) as a valorization biomass for the bioethanol production. Energy 2015, 93, 1742–1747. [Google Scholar] [CrossRef]
- Li, S.; Zhu, D.; Li, K.; Yang, Y.; Lei, Z.; Zhang, Z. Soybean curd residue: Composition, utilization, and related limiting factors. ISRN Ind. Eng. 2013, 2013, 423590. [Google Scholar] [CrossRef]
- Bueno, P.; Tapias, R.; López, F.; Díaz, M. Optimizing composting parameters for nitrogen conservation in composting. Bioresour. Technol. 2008, 99, 5069–5077. [Google Scholar] [CrossRef]
- Luangwilai, T.; Sidhu, H.; Nelson, M.; Chen, X.D. Modelling the Effects of Moisture Content in Compost Piles. CHEMECA, 2011: Australian Chemical Engineering Conference Australia: Engineers Australia. Available online: https://ro.uow.edu.au/infopapers/2049/ (accessed on 30 November 2022).
- Kumar, M.; Ou, Y.-L.; Lin, J.-G. Co-composting of green waste and food waste at low C/N ratio. Waste Manag. 2010, 30, 602–609. [Google Scholar] [CrossRef] [PubMed]
- Iqbal, M.K.; Shafiq, T.; Ahmed, K. Characterization of bulking agents and its effects on physical properties of compost. Bioresour. Technol. 2010, 101, 1913–1919. [Google Scholar] [CrossRef] [PubMed]
- Wu, L.; Ma, L.; Martinez, G. Comparison of methods for evaluating stability and maturity of biosolids compost. J. Environ. Qual. 2000, 29, 424–429. [Google Scholar] [CrossRef]
- Mahapatra, S.; Ali, M.H.; Samal, K. Assessment of compost maturity-stability indices and recent development of composting bin. Energy Nexus 2022, 6, 100062. [Google Scholar] [CrossRef]
- Hue, N.; Liu, J. Predicting compost stability. Compost. Sci. Util. 1995, 3, 8–15. [Google Scholar] [CrossRef]
- Antil, R.S.; Raj, D.; Abdalla, N.; Inubushi, K. Physical, chemical and biological parameters for compost maturity assessment: A review. In Composting for Sustainable Agriculture; Springer: Berlin/Heidelberg, Germany, 2014; pp. 83–101. [Google Scholar]
- Nuzir, F.A.; Hayashi, S.; Takakura, K. Takakura composting method (TCM) as an appropriate environmental technology for urban waste management. Int. J. Build. Urban Inter. Landsc. Technol. 2019, 13, 67–82. [Google Scholar]
- Pottipati, S.; Kundu, A.; Kalamdhad, A.S. Process optimization by combining in-vessel composting and vermicomposting of vegetable waste. Bioresour. Technol. 2022, 346, 126357. [Google Scholar] [CrossRef]
- Mandpe, A.; Yadav, N.; Paliya, S.; Tyagi, L.; Yadav, B.R.; Singh, L.; Kumar, S.; Kumar, R. Exploring the synergic effect of fly ash and garbage enzymes on biotransformation of organic wastes in in-vessel composting system. Bioresour. Technol. 2021, 322, 124557. [Google Scholar] [CrossRef]
- Zhang, X.; Ma, D.; Lv, J.; Feng, Q.; Liang, Z.; Chen, H.; Feng, J. Food waste composting based on patented compost bins: Carbon dioxide and nitrous oxide emissions and the denitrifying community analysis. Bioresour. Technol. 2022, 346, 126643. [Google Scholar] [CrossRef]
- Keng, Z.X.; Chong, S.; Ng, C.G.; Ridzuan, N.I.; Hanson, S.; Pan, G.-T.; Lau, P.L.; Supramaniam, C.V.; Singh, A.; Chin, C.F. Community-scale composting for food waste: A life-cycle assessment-supported case study. J. Clean. Prod. 2020, 261, 121220. [Google Scholar] [CrossRef]
- Vergara, S.E.; Silver, W.L. Greenhouse gas emissions from windrow composting of organic wastes: Patterns and emissions factors. Environ. Res. Lett. 2019, 14, 124027. [Google Scholar] [CrossRef]
- Palaniveloo, K.; Amran, M.A.; Norhashim, N.A.; Mohamad-Fauzi, N.; Peng-Hui, F.; Hui-Wen, L.; Kai-Lin, Y.; Jiale, L.; Chian-Yee, M.G.; Jing-Yi, L. Food waste composting and microbial community structure profiling. Processes 2020, 8, 723. [Google Scholar] [CrossRef]
- Gariglio, N.; Buyatti, M.; Pilatti, R.; Russia, D.G.; Acosta, M. Use of a germination bioassay to test compost maturity of willow (Salix sp.) sawdust. N. Z. J. Crop Hortic. Sci. 2002, 30, 135–139. [Google Scholar] [CrossRef]
- Hassani, N. Using Chicken Manure as Garden Fertilizer. Available online: https://www.thespruce.com/chicken-manure-fertilizer-5189920#:~:text=The%20organic%20matter%20in%20chicken,available%20to%20plants%20more%20quickly (accessed on 29 July 2022).
- Tiquia, S.; Tam, N. Composting of spent pig litter in turned and forced-aerated piles. Environ. Pollut. 1998, 99, 329–337. [Google Scholar] [CrossRef] [PubMed]
- Changa, C.; Wang, P.; Watson, M.; Hoitink, H.; Michel, F., Jr. Assessment of the reliability of a commercial maturity test kit for composted manures. Compost. Sci. Util. 2003, 11, 125–143. [Google Scholar] [CrossRef]
- Woods End Research Laboratory. Guide to Solvita(R) Testing for Compost Maturity Index. Available online: https://cdn.sare.org/wp-content/uploads/20171204134211/982665solvita-compost-test-manual.pdf (accessed on 30 November 2022).
- McGuire, K.L.; D’angelo, H.; Brearley, F.; Gedallovich, S.; Babar, N.; Yang, N.; Gillikin, C.; Gradoville, R.; Bateman, C.; Turner, B.L. Responses of soil fungi to logging and oil palm agriculture in Southeast Asian tropical forests. Microb. Ecol. 2015, 69, 733–747. [Google Scholar] [CrossRef]
- Zhong, X.-Z.; Li, X.-X.; Zeng, Y.; Wang, S.-P.; Sun, Z.-Y.; Tang, Y.-Q. Dynamic change of bacterial community during dairy manure composting process revealed by high-throughput sequencing and advanced bioinformatics tools. Bioresour. Technol. 2020, 306, 123091. [Google Scholar] [CrossRef] [PubMed]
- Partanen, P.; Hultman, J.; Paulin, L.; Auvinen, P.; Romantschuk, M. Bacterial diversity at different stages of the composting process. BMC Microbiol. 2010, 10, 94. [Google Scholar] [CrossRef] [PubMed]
- Zhong, X.-Z.; Ma, S.-C.; Wang, S.-P.; Wang, T.-T.; Sun, Z.-Y.; Tang, Y.-Q.; Deng, Y.; Kida, K. A comparative study of composting the solid fraction of dairy manure with or without bulking material: Performance and microbial community dynamics. Bioresour. Technol. 2018, 247, 443–452. [Google Scholar] [CrossRef]
- Meng, Q.; Yang, W.; Men, M.; Bello, A.; Xu, X.; Xu, B.; Deng, L.; Jiang, X.; Sheng, S.; Wu, X. Microbial community succession and response to environmental variables during cow manure and corn straw composting. Front. Microbiol. 2019, 10, 529. [Google Scholar] [CrossRef]
- McLoud, T.C.; Boiselle, P.M.; Trotman-Dickenson, B. Chapter 9—Diseases of Altered Immunologic Activity. In Thoracic Radiology, 2nd ed.; McLoud, T.C., Boiselle, P.M., Eds.; Mosby: Philadelphia, PA, USA, 2010; pp. 216–241. [Google Scholar]
- Nam, J.-H.; Bae, W.; Lee, D.-H. Oceanobacillus caeni sp. nov., isolated from a Bacillus-dominated wastewater treatment system in Korea. Int. J. Syst. Evol. Microbiol. 2008, 58, 1109–1113. [Google Scholar] [CrossRef][Green Version]
- Wang, C.; Dong, D.; Wang, H.; Müller, K.; Qin, Y.; Wang, H.; Wu, W. Metagenomic analysis of microbial consortia enriched from compost: New insights into the role of Actinobacteria in lignocellulose decomposition. Biotechnol. Biofuels 2016, 9, 22. [Google Scholar] [CrossRef]
- von Jan, M.; Riegger, N.; Pötter, G.; Schumann, P.; Verbarg, S.; Spröer, C.; Rohde, M.; Lauer, B.; Labeda, D.P.; Klenk, H.-P. Kroppenstedtia eburnea gen. nov., sp. nov., a thermoactinomycete isolated by environmental screening, and emended description of the family Thermoactinomycetaceae Matsuo et al. 2006 emend. Yassin et al. 2009. Int. J. Syst. Evol. Microbiol. 2011, 61 Pt 9, 2304–2310. [Google Scholar] [CrossRef]
- Langarica-Fuentes, A.; Zafar, U.; Heyworth, A.; Brown, T.; Fox, G.; Robson, G.D. Fungal succession in an in-vessel composting system characterized using 454 pyrosequencing. FEMS Microbiol. Ecol. 2014, 88, 296–308. [Google Scholar] [CrossRef] [PubMed]
- Di Piazza, S.; Houbraken, J.; Meijer, M.; Cecchi, G.; Kraak, B.; Rosa, E.; Zotti, M. Thermotolerant and thermophilic mycobiota in different steps of compost maturation. Microorganisms 2020, 8, 880. [Google Scholar] [CrossRef] [PubMed]
- Sun, S.; Han, J.; Hu, M.; Gao, M.; Qiu, Q.; Zhang, S.; Qiu, L.; Ma, J. Removal of phosphorus from wastewater by Diutina rugosa BL3: Efficiency and pathway. Sci. Total Environ. 2021, 801, 149751. [Google Scholar] [CrossRef]
- Statzell-Tallman, A.; Scorzetti, G.; Fell, J.W. Candida spencermartinsiae sp. nov., Candida taylorii sp. nov. and Pseudozyma abaconensis sp. nov., novel yeasts from mangrove and coral reef ecosystems. Int. J. Syst. Evol. Microbiol. 2011, 61, 1760–1761. [Google Scholar] [CrossRef]
- Soto-Paz, J.; Oviedo-Ocaña, E.R.; Manyoma-Velásquez, P.C.; Torres-Lozada, P.; Gea, T. Evaluation of mixing ratio and frequency of turning in the co-composting of biowaste with sugarcane filter cake and star grass. Waste Manag. 2019, 96, 86–95. [Google Scholar] [CrossRef]
- Jiang, Y.; Liu, J.; Huang, Z.; Li, P.; Ju, M.; Zhan, S.; Wang, P. Air bag bioreactor to improve biowaste composting and application. J. Clean. Prod. 2019, 237, 117797. [Google Scholar] [CrossRef]
- Thomas, A.R.; Arulraj, P.R.; Kranert, M.; Philip, L. Investigation on greenhouse gas emissions and compost dynamics during in-vessel co-composting of septage and mixed organic wastes. Int. J. Environ. Sci. Technol. 2020, 17, 1675–1690. [Google Scholar] [CrossRef]
- Zhang, H.; Wang, L.; Tan, Y.; Wang, H.; Yang, F.; Chen, L.; Hao, F.; Lv, X.; Du, H.; Xu, Y. Effect of Pichia on shaping the fermentation microbial community of sauce-flavor Baijiu. Int. J. Food Microbiol. 2021, 336, 108898. [Google Scholar] [CrossRef]
- Soto-Paz, J.; Alfonso-Morales, W.; Caicedo-Bravo, E.; Oviedo-Ocaña, E.R.; Torres-Lozada, P.; Manyoma, P.C.; Sanchez, A.; Komilis, D. A New Approach for the Optimization of Biowaste Composting Using Artificial Neural Networks and Particle Swarm Optimization. Waste Biomass Valorization 2020, 11, 3937–3951. [Google Scholar] [CrossRef]

| Component of Compost Mixture | Organic Material |
|---|---|
| Substrate | Soybean curd residue (SCR) |
| Amendment agent | Chicken manure and others [dataset] |
| Bulking agent | Sawdust |
| Parameters | Method Reference | Soybean Curd Residue | Dewatered Soybean Curd Residue | Sawdust |
|---|---|---|---|---|
| Moisture Content (%) | AOAC931.04 | 89 | 82 | 27 |
| pH at 25 °C | AOAC945.10 | 4.15 | 4.18 | 7.15 |
| Organic Matter (%) | MS 417: Part 8: 1997 | 95 | 96 | 98 |
| Total Organic Carbon (%) | MS 417: Part 8: 1997 | 56 | 56 | 57 |
| Total Kjeldahl Nitrogen (%) | MS 417: Part 3: 1994 & AOAC991.20 | 4.1 | 3.6 | 0.4 |
| Ash Content (%) | USP 24NF19 | 3.9 | 7.0 | 2.2 |
| C/N Ratio (TOC/TKN) | Calculation | 14.3 | 16.1 | 153.2 |
| Substrate/Agent | Constraint |
|---|---|
| SCR | 100–300 tonnes/cycle |
| Dewatered SCR | 50–150 tonnes/cycle |
| Amendment agent | 100–200 tonnes/cycle |
| Sawdust | 40–120 tonnes/cycle |
| Total weight | 500 tonnes |
| Total volume | 700 m3 |
| Sample | CO2 Result | NH3 Result | Compost Maturity Index |
|---|---|---|---|
| 3rd-month compost | 3 | 5 | 3 |
| 4th-month compost | 4 | 4 | 4 |
| 5th-month compost | 5 | 5 | 5 |
| 6th-month compost | 6 | 5 | 6 |
| Composting Duration | Sample ID | Percentage of Compost Extract | Average Number of Seeds Germinated | Average Root Length (mm) | Germination Index (Gi) | Global Germination Index (GI) |
|---|---|---|---|---|---|---|
| 3 months | 1.1 | 0 | 54.5 | 53 | 100 | 0 |
| 1.2 | 25 | 0 | 0 | 0 | ||
| 1.3 | 50 | 0 | 0 | 0 | ||
| 1.4 | 75 | 0 | 0 | 0 | ||
| 1.5 | 100 | 0 | 0 | 0 | ||
| 4 months | 2.1 | 0 | 54 | 51 | 100 | 1.46 |
| 2.2 | 25 | 14 | 11.5 | 5.85 | ||
| 2.3 | 50 | 11.5 | 7 | 2.92 | ||
| 2.4 | 75 | 0 | 0 | 0 | ||
| 2.5 | 100 | 0 | 0 | 0 | ||
| 5 months | 3.1 | 0 | 51.5 | 50 | 100 | 10.00 |
| 3.2 | 25 | 35.5 | 47.5 | 65.49 | ||
| 3.3 | 50 | 10 | 51.5 | 20.00 | ||
| 3.4 | 75 | 0 | 0 | 0 | ||
| 3.5 | 100 | 0 | 0 | 0 | ||
| 6 months | 4.1 | 0 | 47 | 48 | 100 | 58.94 |
| 4.2 | 25 | 53 | 52 | 122.16 | ||
| 4.3 | 50 | 29 | 52 | 66.84 | ||
| 4.4 | 75 | 23.5 | 49 | 51.04 | ||
| 4.5 | 100 | 7.5 | 51.5 | 17.12 | ||
| 7 months | 5.1 | 0 | 47.5 | 48 | 100 | 111.97 |
| 5.2 | 25 | 48.5 | 61.5 | 130.82 | ||
| 5.3 | 50 | 52.5 | 57 | 131.25 | ||
| 5.4 | 75 | 39.5 | 53.5 | 92.69 | ||
| 5.5 | 100 | 20 | 51.5 | 45.18 |
| Month(s) | Bacteria | Fungi |
|---|---|---|
| Common microbes | ||
| 2nd, 4th, and 7th months | s__Oceanobacillus_caeni, g(U)_Acetobacter, g(U)_Corynebacterium, g(U)_Corynebacterium, g(U)_Acetobacter | g(U)_Aspergillus, s__Thermomyces_dupontii, g(U)_Aspergillus, g(U)_Aspergillus, s__Thermomyces_dupontii |
| 2nd and 4th months | f(U)_Thermoactinomycetaceae, s__Bacillus_O_smithii, s__Chishuiella_changwenlii, c(U)_Bacilli, f(U)_Streptosporangiaceae | s__Thermoascus_crustaceus, s__Thermomyces_stellatus |
| 4th and 7th months | g(U)_Corynebacterium, g(U)_Corynebacterium, s__Corynebacterium_phoceense, g(U)_Corynebacterium, g(U)_Staphylococcus | g(U)_Thermomyces, g(U)_Aspergillus |
| 2nd and 7th months | g(U)_Limosilactobacillus, s__Myroides_sp004151275, s__Clostridium_V_ultunense, g(U)_Lactobacillus, g(U)_Sphingobacterium | g(U)_Aspergillus, s__Rhodotorula_toruloides |
| Unique microbes | ||
| 2nd month | g(U)_Acetobacter, g(U)_Acetobacter, g(U)_Nocardiopsis, s__Thermoactinomyces_vulgaris, g(U)_Acinetobacter | s__Diutina_rugosa, f(U)_Saccharomycetales_fam_Incertae_sedis, s__Diutina_rugosa, p(U)_Ascomycota, f(U)_Saccharomycetales_fam_Incertae_sedis |
| 4th month | f(U)_Thermoactinomycetaceae, s__Oceanobacillus_caeni, g(U)_Saccharopolyspora, s__Lentibacillus_sp902806455, f(U)_Amphibacillaceae | s__Thermomyces_dupontii, s__Thermoascus_crustaceus, s__Thermomyces_dupontii, s__Candida_taylorii, g(U)_Aspergillus |
| 7th month | s__Kroppenstedtia_eburnea, g(U)_Corynebacterium, o(U)_Bacillales_B, g(U)_Corynebacterium, g(U)_Gordonia | s__Thermomyces_dupontii, g(U)_Melanocarpus, g(U)_Polypaecilum, s__Aspergillus_heterocaryoticus, g(U)_Sterigmatomyces |
Disclaimer/Publisher’s Note: The statements, opinions and data contained in all publications are solely those of the individual author(s) and contributor(s) and not of MDPI and/or the editor(s). MDPI and/or the editor(s) disclaim responsibility for any injury to people or property resulting from any ideas, methods, instructions or products referred to in the content. |
© 2023 by the authors. Licensee MDPI, Basel, Switzerland. This article is an open access article distributed under the terms and conditions of the Creative Commons Attribution (CC BY) license (https://creativecommons.org/licenses/by/4.0/).
Share and Cite
Keng, Z.X.; Tan, J.J.M.; Phoon, B.L.; Khoo, C.C.; Khoiroh, I.; Chong, S.; Supramaniam, C.; Singh, A.; Pan, G.-T. Aerated Static Pile Composting for Industrial Biowastes: From Engineering to Microbiology. Bioengineering 2023, 10, 938. https://doi.org/10.3390/bioengineering10080938
Keng ZX, Tan JJM, Phoon BL, Khoo CC, Khoiroh I, Chong S, Supramaniam C, Singh A, Pan G-T. Aerated Static Pile Composting for Industrial Biowastes: From Engineering to Microbiology. Bioengineering. 2023; 10(8):938. https://doi.org/10.3390/bioengineering10080938
Chicago/Turabian StyleKeng, Zi Xiang, Jamie Jean Minn Tan, Bao Lee Phoon, Chee Chang Khoo, Ianatul Khoiroh, Siewhui Chong, Christinavimala Supramaniam, Ajit Singh, and Guan-Ting Pan. 2023. "Aerated Static Pile Composting for Industrial Biowastes: From Engineering to Microbiology" Bioengineering 10, no. 8: 938. https://doi.org/10.3390/bioengineering10080938
APA StyleKeng, Z. X., Tan, J. J. M., Phoon, B. L., Khoo, C. C., Khoiroh, I., Chong, S., Supramaniam, C., Singh, A., & Pan, G.-T. (2023). Aerated Static Pile Composting for Industrial Biowastes: From Engineering to Microbiology. Bioengineering, 10(8), 938. https://doi.org/10.3390/bioengineering10080938













